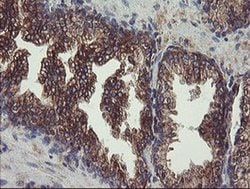
UBE2J1 Monoclonal Antibody (OTI1F6), TrueMAB , OriGene 100 &mu;L | Buy Online | Origene Technologies | Fisher Scientific

missing translation for 'onlineSavingsMsg'
Learn More
Learn More
UBE2J1 Monoclonal Antibody (OTI1F6), TrueMAB™, OriGene

Descripción
The modification of proteins with ubiquitin is an important cellular mechanism for targeting abnormal or short-lived proteins for degradation. Ubiquitination involves at least three classes of enzymes: ubiquitin-activating enzymes, or E1s, ubiquitin-conjugating enzymes, or E2s, and ubiquitin-protein ligases, or E3s. This gene encodes a member of the E2 ubiquitin-conjugating enzyme family. This enzyme is located in the membrane of the endoplasmic reticulum and may contribute to quality control ER-associated degradation by the ubiquitin-proteasome system.
Especificaciones
Especificaciones
| Antígeno | UBE2J1 |
| Aplicaciones | Flow Cytometry, Immunohistochemistry (Paraffin), Western Blot |
| Clasificación | Monoclonal |
| Clon | OTI1F6 |
| Concentración | 1 mg/mL |
| Conjugado | Unconjugated |
| Formulación | PBS with 1% BSA, 50% glycerol and 0.02% sodium azide |
| génica | UBE2J1 |
| N.º de referencia del gen | Q9Y385 |
| Alias de gen | CGI-76, HSPC153, HSPC205, HSU93243, NCUBE-1, NCUBE1, UBC6, UBC6E, Ubc6p |
| Mostrar más |
Título del producto
Al hacer clic en Enviar, acepta que Fisher Scientific se ponga en contacto con usted en relación con los comentarios que ha proporcionado en este formulario. No compartiremos su información para ningún otro fin. Toda la información de contacto proporcionada se mantendrá de acuerdo con nuestra Política de Privacidad. Política de privacidad.
¿Detecta una oportunidad de mejora?